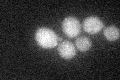
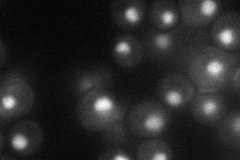
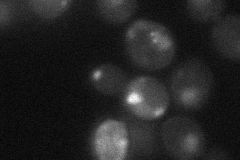

View description
Component of the RSC chromatin remodeling complex; required for expression of mid-late sporulation-specific genes; contains two essential bromodomains, a bromo-adjacent homology (BAH) domain, and an AT hook
Localization:
Intensity:
Fold change:
Significance:
-
C’ GFP library in SD
cytosol20.34 -
N' NOP1pr-GFP in SD
nucleus38.087 -
N' TEF2pr-mCherry in SD

nucleus17.3152 -
N' NATIVEpr-GFP in SD

nucleus34.0609 -
N' TEF2pr-VC and Cyto-VN in SD
punctate,nucleus28.38 -
C’ GFP library in SD+DTT

cytosol23.341.14No -
C’ GFP library in SD+H2O2

cytosol21.451.05No -
C’ GFP library in Starvation Media

cytosol16.410.8No -
C’ GFP library on the background of Pup2-DaMP

cytosol -
C’ GFP library on the background of CCT mutant

cytosol21.45961.05462No
